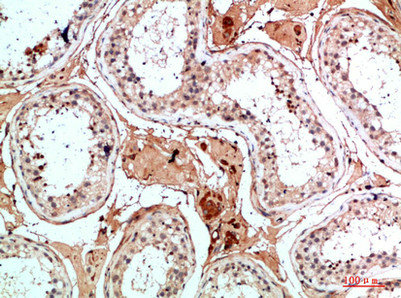

NANOS1 Antibody
-
中文名稱:NANOS1兔多克隆抗體
-
貨號:CSB-PA642015
-
規格:¥1090
-
圖片:
-
Western Blot analysis of 3T3 cells using Nanos Homologue 1 (NANOS1) Polyclonal Antibody diluted at 1:1500. Secondary antibody was diluted at 1:20000
-
Western Blot analysis of various cells using Antibody diluted at 1:1000. Secondary antibody was diluted at 1:20000
-
Immunohistochemical analysis of paraffin-embedded human-breast-cancer, antibody was diluted at 1:200
-
Immunohistochemical analysis of paraffin-embedded human-breast-cancer, antibody was diluted at 1:200
-
Immunohistochemical analysis of paraffin-embedded human-testis, antibody was diluted at 1:200
-
Immunohistochemical analysis of paraffin-embedded human-testis, antibody was diluted at 1:200
-
-
其他:
產品詳情
-
Uniprot No.:
-
基因名:NANOS1
-
別名:EC Rep1a antibody; EC_Rep1a antibody; NANO1_HUMAN antibody; NANOS 1 antibody; Nanos homolog 1 (Drosophila) antibody; Nanos homolog 1 antibody; Nanos Homologue 1 (NANOS1) antibody; NANOS1 antibody; Nos 1 antibody; NOS-1 antibody; Nos1 antibody; OTTHUMP00000046853 antibody; Rep 1a antibody; Rep1a antibody
-
宿主:Rabbit
-
反應種屬:Human
-
免疫原:Synthesized peptide derived from Nanos Homologue 1 (NANOS1) at AA range: 151-200
-
免疫原種屬:Homo sapiens (Human)
-
標記方式:Non-conjugated
-
純化方式:The antibody was affinity-purified from rabbit antiserum by affinity-chromatography using epitope-specific immunogen.
-
濃度:It differs from different batches. Please contact us to confirm it.
-
保存緩沖液:Liquid in PBS containing 50% glycerol, 0.5% BSA and 0.02% sodium azide.
-
產品提供形式:Liquid
-
應用范圍:WB,ELISA
-
推薦稀釋比:
Application Recommended Dilution WB 1:500-2000 ELISA 1:10000-20000 -
Protocols:
-
儲存條件:Upon receipt, store at -20°C or -80°C. Avoid repeated freeze.
-
貨期:Basically, we can dispatch the products out in 1-3 working days after receiving your orders. Delivery time maybe differs from different purchasing way or location, please kindly consult your local distributors for specific delivery time.
-
用途:For Research Use Only. Not for use in diagnostic or therapeutic procedures.
相關產品
靶點詳情
-
功能:May act as a translational repressor which regulates translation of specific mRNAs by forming a complex with PUM2 that associates with the 3'-UTR of mRNA targets. Capable of interfering with the proadhesive and anti-invasive functions of E-cadherin. Up-regulates the production of MMP14 to promote tumor cell invasion.
-
基因功能參考文獻:
- High NANOS expression is associated with retinoblastoma. PMID: 25100735
- A group of 195 patients manifesting non-obstructive azoospermia or oligozoospermia were tested for mutations of the NANOS1 gene. PMID: 23315541
- Single nucleotide polymorphisms in CYP26B1, NANOS1 and STRA8 genes support involvement of meiotic program initiation in modifying azoospermia and oligozoospermia risk in a Han-Chinese population PMID: 23320086
- NANOS1-PUMILIO2 complex, together with GEMIN3 and small noncoding RNAs, possibly regulate mRNA translation within the chromatoid body of the human germ cells. PMID: 21800163
- Findings describe a new function for hNanos1 as a downstream effector of E-cadherin loss contributing to tumor progression. PMID: 17047063
- The E-cadherin-repressed hNanos1 gene induces tumor cell invasion by upregulating MT1-MMP expression. PMID: 18223680
- Data demonstrated that SNAPIN interacts additionally with NANOS1 protein. This is the first report demonstrating that the N-terminal region of NANOS1 is necessary for protein binding. PMID: 19168546
顯示更多
收起更多
-
相關疾病:Spermatogenic failure 12 (SPGF12)
-
亞細胞定位:Cytoplasm, perinuclear region. Cytoplasm.
-
蛋白家族:Nanos family
-
組織特異性:Testis and ovary (at protein level). Predominantly expressed in testis. Specifically expressed during germline development. In adult tissues, it is mainly expressed in spermatogonia, the stem cells of the germline. Also expressed during meiosis in spermat
-
數據庫鏈接:
Most popular with customers
-
-
YWHAB Recombinant Monoclonal Antibody
Applications: ELISA, WB, IHC, IF, FC
Species Reactivity: Human, Mouse, Rat
-
Phospho-YAP1 (S127) Recombinant Monoclonal Antibody
Applications: ELISA, WB, IHC
Species Reactivity: Human
-
-
-
-
-